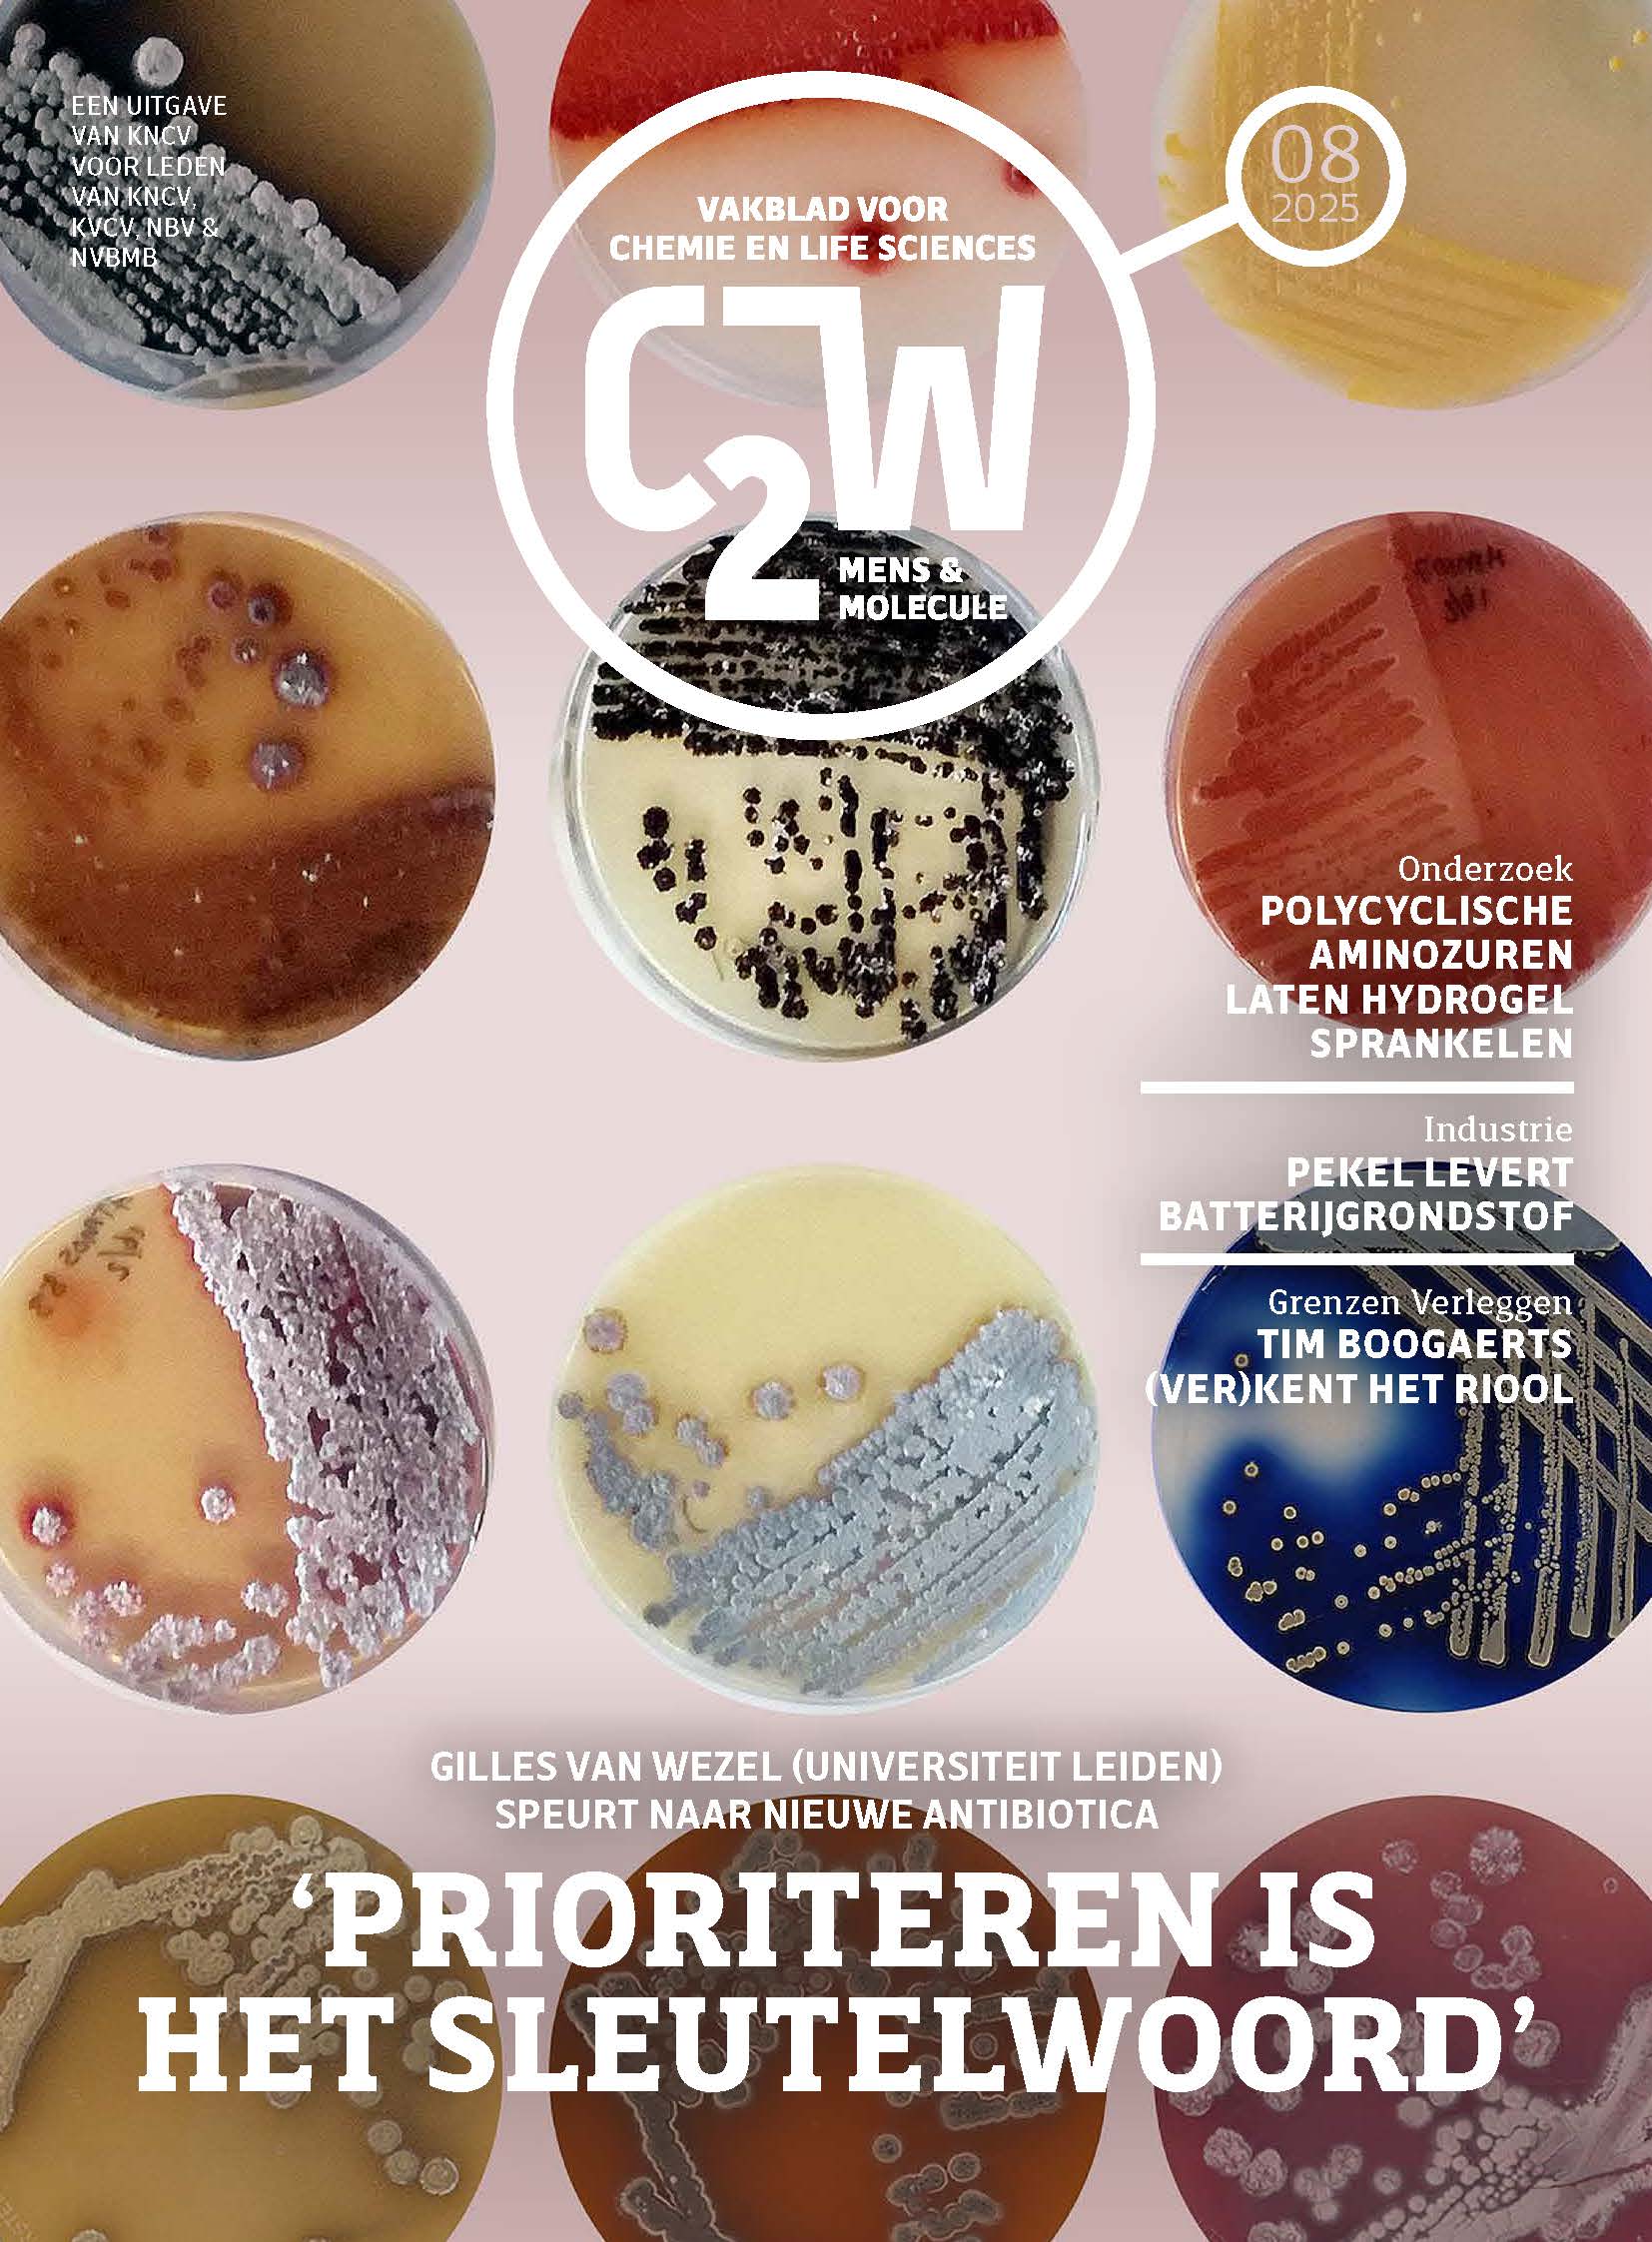
memo_2025_08.jpg

C2W | Mens & Molecule
|
C2W | Mens & Molecule C2W | Mens & Molecule is the membership magazine of the KVCV (in Dutch). It appears 8 times per year and informs the readers about recent developments in chemistry and related disciplines such as instrumentation, life sciences, process technology, laboratory technology and molecular sciences. C2W | Mens & Molecule reports on developments in universities and research laboratories as well as on developments within companies and commercial chemistry organisations. There is a strong focus on the Netherlands and Flanders. The magazine is edited by an independent editorial board composed of professional journalists and editors with a thorough knowledge of chemistry and related disciplines. C2W | Mens & Molecule for libraries Libraries that subscribe to the scientific journal C2W | Mens & Molecule, Magazine for Chemistry and Biosciences, which includes the KVCV pages, pay € 60 (incl. 6% VAT) per desired copy. C2W | Mens & Molecule is published 8 times a year. Subscribe to C2W | Mens & Molecule sciencelink.net At sciencelink.net you can find these and other articles online. As a KVCV member you have unlimited access to this content. Ideas for C2W | Mens & Molecule We welcome any ideas for the content of C2W | Mens & Molecule, such as topics for background articles or opinions, developments in research or education, persons, research institutions, achievements of companies or events related to the topics of the planned issues. Suggestions can be sent to the editorial office via This email address is being protected from spambots. You need JavaScript enabled to view it. with cc to This email address is being protected from spambots. You need JavaScript enabled to view it.. |
|
Contributions to the KVCV pages
KVCV divisions or people who want to include a contribution in the KVCV pages can send this to This email address is being protected from spambots. You need JavaScript enabled to view it. Attn Christophe De Bie, before the deadline mentioned below. Information that is sent overdue will be included in a next issue.
2026
|
Number
|
Dates of appearance
|
Deadline for contributions
|
| nr. 1 |
03-02-2026
|
> 02-01-2026
|
| nr. 2 |
10-03-2026
|
> 06-02-2026
|
| nr. 3 |
21-04-2026
|
> 16-03-2026
|
| nr. 4 | 02-06-2026 | > 27-04-2026 |
| nr. 5 |
07-07-2026
|
> 05-06-2026
|
| nr. 6 |
08-09-2026
|
> 07-08-2026
|
| nr. 7 | 06-10-2026 | > 04-09-2026 |
| nr. 8 |
15-12-2026
|
> 13-11-2026
|